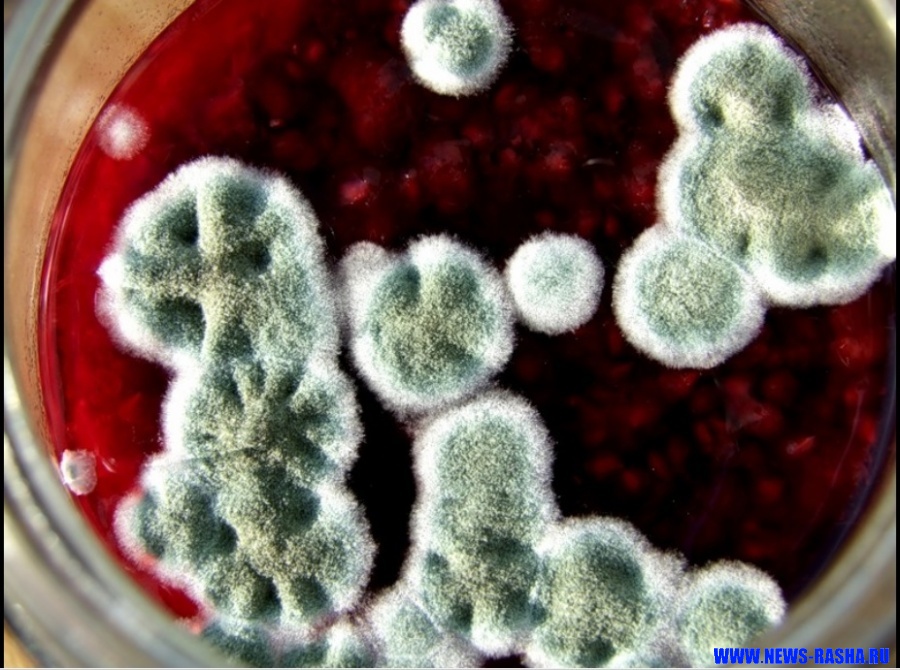

Грибной дождь
Грибной дождь.
Первая радуга начинается с синего спектра, заканчивается красным. Вторая радуга, с большим радиусом, как продолжение первой, начинается с красного через пустой промежуток и кончается синим, тем же спектром с которого начиналась первая радуга.
Я вот думаю, как консервировать варенье, чтобы оно не портилось?
Варенье = 2 000 000
Грибок = 65 000 000
Красный спектр -почва для грибка.
Крышка полителеновая хуже, металлическая лучше. А может просто класть кружок фольги от грибка на варенье? И мне кажется горячие банки хуже закрывать, на крышке образуется конденсат, который может быть питательной средой для грибка. Хотя конденсат и должен быть чистым, как дистиллированная вода. Но я думаю всё же дело как раз в этом конденсате. При этом конденсат от металлической крышки другой - конденсат с "луны" с синим спектром. Роса бывает красная..
От металлической крышки синий спектр излучения, от полителеновой красный. Грибы не любят синий. На фольге образуется синий спектр. Положу фольгу с полителеновой крышкой, проверю.
Это мысль про варенье навела на другую, про спектр от земли в зависимости от осадков и разного время года.
Дожди бывают разные. Бывает первый весенний, бывает грибной, слепой, косой, прямой, бывает осенний. Небо меняет цвет, и капли меняют окраску, падая на землю они окрашивают её в разные цвета.
Сделала опыт с конденсатом от кипятка
Налила кипяток в стакан и накрываю разными крышками.
Сейчас посмотрю, как окрасится кипяток от конденсата с разных крышек.
стакан с полителеновой крышкой = 17 000
стакан с полителеновой крышкой и фольгой = 17 000
стеклянная крышка = 17 000
металлическая хромированная крышка = 17 000
закручивающаяся крышка с резьбой= 17 000
металлическая жёлтая крышка = 17 000
Что можно ещё сказать, что весной земля синяя после осенних дождей и растаявшего снега, и эта земля даёт ростки, возбуждает семена к росту. Летом дожди с красного неба красные, окрашивают землю в красный цвет, и к осени это хорошо видно в опавшей листве много красного спектра, земля становится красной. Природа замирает, не даёт новых проростков, но зато к осени хорошо растут грибы, им красная земля по вкусу. Грибы любят опавшую листву.
Яблоки падают в небо.
Первая радуга начинается с синего спектра, заканчивается красным. Вторая радуга, с большим радиусом, как продолжение первой, начинается с красного через пустой промежуток и кончается синим, тем же спектром с которого начиналась первая радуга.
Я вот думаю, как консервировать варенье, чтобы оно не портилось?
Варенье = 2 000 000
Грибок = 65 000 000
Красный спектр -почва для грибка.
Крышка полителеновая хуже, металлическая лучше. А может просто класть кружок фольги от грибка на варенье? И мне кажется горячие банки хуже закрывать, на крышке образуется конденсат, который может быть питательной средой для грибка. Хотя конденсат и должен быть чистым, как дистиллированная вода. Но я думаю всё же дело как раз в этом конденсате. При этом конденсат от металлической крышки другой - конденсат с "луны" с синим спектром. Роса бывает красная..
От металлической крышки синий спектр излучения, от полителеновой красный. Грибы не любят синий. На фольге образуется синий спектр. Положу фольгу с полителеновой крышкой, проверю.
Это мысль про варенье навела на другую, про спектр от земли в зависимости от осадков и разного время года.
Дожди бывают разные. Бывает первый весенний, бывает грибной, слепой, косой, прямой, бывает осенний. Небо меняет цвет, и капли меняют окраску, падая на землю они окрашивают её в разные цвета.
Сделала опыт с конденсатом от кипятка
Налила кипяток в стакан и накрываю разными крышками.
Сейчас посмотрю, как окрасится кипяток от конденсата с разных крышек.
стакан с полителеновой крышкой = 17 000
стакан с полителеновой крышкой и фольгой = 17 000
стеклянная крышка = 17 000
металлическая хромированная крышка = 17 000
закручивающаяся крышка с резьбой= 17 000
металлическая жёлтая крышка = 17 000
Что можно ещё сказать, что весной земля синяя после осенних дождей и растаявшего снега, и эта земля даёт ростки, возбуждает семена к росту. Летом дожди с красного неба красные, окрашивают землю в красный цвет, и к осени это хорошо видно в опавшей листве много красного спектра, земля становится красной. Природа замирает, не даёт новых проростков, но зато к осени хорошо растут грибы, им красная земля по вкусу. Грибы любят опавшую листву.
Яблоки падают в небо.
Колыбельная четырех дождей
Дождевая вода
Почему дождевая вода является намного более производительной, регенеративной и увеличивает рост чем поливная вода.
В то время как ливень не всегда достигает высшей точки в разряде молнии, которая зависит (как см ниже) от преобладающих условий и плотности водяного пара, как эти небольшие диполи падают и вращаются, создавая и электрическое и магнитное, или биомагнитное поле, формирующую энергичную область. Когда эта теперь высоко-заряженная капля дождя встречает живой организм, в данном случае лист, её накопленная энергия сбрасывается на растение и делается непосредственно доступной для использования растениями. Это - причина для более энергичной реакции растений на дождевую воду в отношении поливной воды, потому что последняя не имеет того же самого расстояния падения, и поэтому не может накопить никакого существенного заряда.
Если этот эксперимент выполнялся в темноте, то можно было увидеть капли воды мощным факелом, поднимающиеся вверх выше верха коллекторов-цилиндров, дающих эффект вертикальных синевато- белых перьев, холодного свечения, в результате интенсивной ионизации ,
Если вместо верхних коллекторов - цилиндров, выше отверстия крана для воды, установливались горизонтально расположенные спирали из медного прута, это давало начало другому феномену, горизонтальному красноватому свечению ниже медных спиралей.
Синий свет связан с биомагнетизмом - созидательной, левитативной энергией жизни, а красноватый свет - продукт электрицизма и имеет дегенеративный выраждающий эффект.
Кроме интереса к генерируему заряду, Виктор Шаубергер также использовал этот аппарат, чтобы проверить качество и живительность воды. Один литр качественной, воды из горного источника должен был пройти через иглу струёй приблизительно 150 раз прежде, чем фольга золотого листа прекращала колебаться. Экспериментируя с изменением температуры воды, он также обнаружил, что при +37°C кислород в воде делается агрессивным и вода, становилась почти непригодной для питья. Её заряд также снижался с ростом температуры. Не сообщалось о цвете ионизированного свечения, описанного выше, подобного Северному сиянию, изменения от температуры. Можно было однако предположить с определённой долей уверенности, что различные температуры производят различные эманации.
Энергия Жизни.
Почему дождевая вода является намного более производительной, регенеративной и увеличивает рост чем поливная вода.
В то время как ливень не всегда достигает высшей точки в разряде молнии, которая зависит (как см ниже) от преобладающих условий и плотности водяного пара, как эти небольшие диполи падают и вращаются, создавая и электрическое и магнитное, или биомагнитное поле, формирующую энергичную область. Когда эта теперь высоко-заряженная капля дождя встречает живой организм, в данном случае лист, её накопленная энергия сбрасывается на растение и делается непосредственно доступной для использования растениями. Это - причина для более энергичной реакции растений на дождевую воду в отношении поливной воды, потому что последняя не имеет того же самого расстояния падения, и поэтому не может накопить никакого существенного заряда.
Если этот эксперимент выполнялся в темноте, то можно было увидеть капли воды мощным факелом, поднимающиеся вверх выше верха коллекторов-цилиндров, дающих эффект вертикальных синевато- белых перьев, холодного свечения, в результате интенсивной ионизации ,
Если вместо верхних коллекторов - цилиндров, выше отверстия крана для воды, установливались горизонтально расположенные спирали из медного прута, это давало начало другому феномену, горизонтальному красноватому свечению ниже медных спиралей.
Синий свет связан с биомагнетизмом - созидательной, левитативной энергией жизни, а красноватый свет - продукт электрицизма и имеет дегенеративный выраждающий эффект.
Кроме интереса к генерируему заряду, Виктор Шаубергер также использовал этот аппарат, чтобы проверить качество и живительность воды. Один литр качественной, воды из горного источника должен был пройти через иглу струёй приблизительно 150 раз прежде, чем фольга золотого листа прекращала колебаться. Экспериментируя с изменением температуры воды, он также обнаружил, что при +37°C кислород в воде делается агрессивным и вода, становилась почти непригодной для питья. Её заряд также снижался с ростом температуры. Не сообщалось о цвете ионизированного свечения, описанного выше, подобного Северному сиянию, изменения от температуры. Можно было однако предположить с определённой долей уверенности, что различные температуры производят различные эманации.
This explains, for instance, why rainwater is much more productive, regenerative and growth-enhancing than irrigation water. While rainfall does not always culminate in a discharge of lightning, which depends (as discussed later) on the prevailing conditions and density of water vapour, as this little dipole falls, it rotates, building up both an electric and a magnetic, or bio-magnetic field, the formative energetic field. When this now highly-charged raindrop encounters a living organism, in this case a leaf, its accumulated energy is discharged into the plant and is made directly available for the plant's use. This is the reason for the more vigorous reaction of plants to rainwater vis- a-vis irrigation water, because the latter does not have the same fall-distance, and there- fore cannot accumulate any significant charge.
If this experiment is carried out in the dark, then with a powerful torch, the water droplets can be seen to rise upwards above the upper collector-cylinders. If horizontally disposed spirals of copper rod are installed in lieu of the upper collector- cylinders, this apparently gives rise to another phenomenon namely the appearance of vertical plumes of bluish and white, cold light above the water-jet the result of intense ionisation and the horizontal propagation of a reddish glow below the copper spirals. The blue light is associated with biomagnetism - the upbuilding, levitational life-energy - and the reddish light is the product of electricism and has a degenerative effect.
If this experiment is carried out in the dark, then with a powerful torch, the water droplets can be seen to rise upwards above the upper collector-cylinders. If horizontally disposed spirals of copper rod are installed in lieu of the upper collector- cylinders, this apparently gives rise to another phenomenon namely the appearance of vertical plumes of bluish and white, cold light above the water-jet the result of intense ionisation and the horizontal propagation of a reddish glow below the copper spirals. The blue light is associated with biomagnetism - the upbuilding, levitational life-energy - and the reddish light is the product of electricism and has a degenerative effect.
Энергия Жизни.
Спойлер
Система сбора дождевой воды
Спойлер
Отвечать в темах могут только зарегистрированные пользователи. Вход • Регистрация.